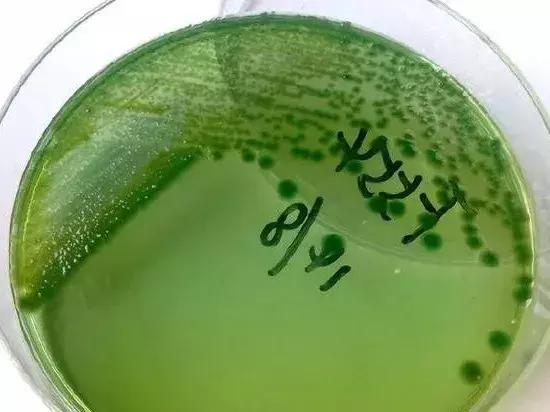
水产养殖弧菌怎么处理,水产弧菌怎么预防

弧菌是水产养殖过程中一种最主要的有害细菌,大部分水产养殖疾病都是由弧菌感染引起的。虾壳溃烂,烂尾烂鳃等等症状都跟弧菌感染有莫大的关系。因此如何抑制弧菌显得至关重要。
弧菌形成繁殖优势的条件:
这里需要注意一点的就是弧菌只有形成繁殖优势才能够感染危害虾,一般养殖环境里面的弧菌达不到繁殖优势的时候,对小龙虾是没有危害的。而弧菌要形成繁殖优势,有几个至关重要的条件,高温天气,溶氧量缺乏,有机物过剩,这三个前提条件缺一不可,在这个前提条件下,弧菌会在厌氧环境下,有机质分解的过程中,挤压耗氧有益菌的生长空间,数量逐渐增多。
针对以上分析,可以得出抑制弧菌主要从两方面入手:
1.以药治菌:这种方法治理弧菌主要使用化学药品,一般选择生石灰和二氧化氯溶液。由于生石灰对鱼虾具有很大的腐蚀作用,所以在高温天气下水体里面有小龙虾活动的情况下,一般不建议使用生石灰清塘改底。
2.以菌治菌:利用特定的生物菌来抑制甚至吞噬弧菌,也是水产养殖过程中一种比较好的方法。根据实际经验,一般有两种方式:一是光合菌+em菌来通过自身大量繁殖,形成优势来挤压弧菌的生存空间,最终达到抑制弧菌大目的。
二是往水体里面投放适量的蛭弧菌来直接吞噬弧菌和其他细菌。蛭弧菌号称细菌界的刺客,可以寄生在所有细菌体内,通过破坏细菌的细胞壁来杀死细菌。

笔者曾亲眼目睹几百万的养殖项目一夜之间全没了,特别是高密度人工育苗期间。菌弧在国家没限制前用氯霉素原粉,单位水体1一2PPm,有技术性使用效果特好。现在用氯霉素的替代品一一氟苯尼考,效果也很好,但要注意使用方法。或者针对养殖对象的品种,对抗渗透压来防制,淡水咸水互换。大面积养殖的,一定要保护池底,定期用生石灰投底(养殖对象要适应,这个要确定。)饲料中添加乐畅桉树精油,其体视情况而定。
养殖水体瞬息万变,重中之重以预防为主,一旦发病都是难以快迅解决,既使解决了,最少要影响一周到半个月的摄食,那结果大家就都知道了。因此,对弧菌最好的方法不是治,而是预防,而养殖中最适用就是控制池底和调节水质,使弧菌没有大量繁殖的空间和机会。